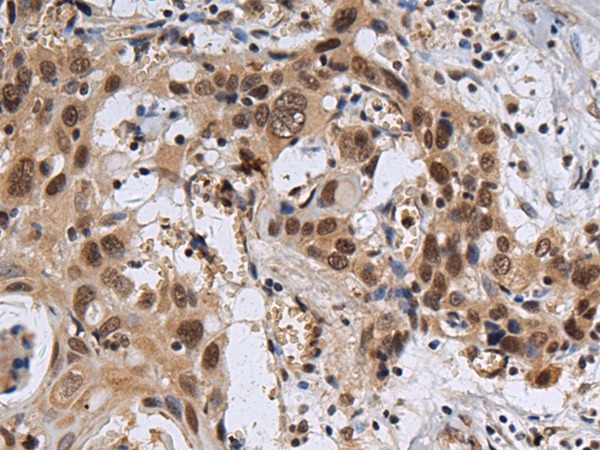

中文名稱: 兔抗ZNF821多克隆抗體
|
Background: |
This gene encodes a protein with two C2H2 zinc finger motifs and a score-and-three (23)-amino acid peptide repeat (STPR) domain. The STPR domain of the encoded protein binds to double stranded DNA and may also contain a nuclear localization signal, suggesting that this protein interacts with chromosomal DNA. Alternatively spliced transcript variants encoding multiple isoforms have been observed for this gene. [provided by RefSeq, Jan 2011] |
|
Applications: |
ELISA, IHC |
|
Name of antibody: |
ZNF821 |
|
Immunogen: |
Fusion protein of human ZNF821 |
|
Full name: |
zinc finger protein 821 |
|
SwissProt: |
O75541 |
|
ELISA Recommended dilution: |
5000-10000 |
|
IHC positive control: |
Human esophagus cancer |
|
IHC Recommend dilution: |
100-300 |
購物車
購物車 幫助
幫助
 021-54845833/15800441009
021-54845833/15800441009
